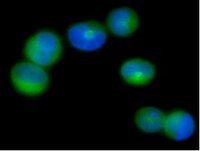

Structural basis for the co-activation of protein kinase B by T-cell leukemia-1 (TCL1) family proto-oncoproteins.
Auguin, Daniel, et al.
J. Biol. Chem., 279: 35890-902 (2004)
2004
Abstract anzeigen
Chromosomal translocations leading to overexpression of p14(TCL1) and its homologue p13(MTCP1) are hallmarks of several human T-cell malignancies (1). p14(TCL1)/p13(MTCP1) co-activate protein kinase B (PKB, also named Akt) by binding to its pleckstrin homology (PH) domain, suggesting that p14(TCL1)/p13(MTCP1) induce T-cell leukemia by promoting anti-apoptotic signals via PKB (2, 3). Here we combined fluorescence anisotropy, NMR, and small angle x-ray-scattering measurements to determine the affinities, molecular interfaces, and low resolution structure of the complex formed between PKBbeta-PH and p14(TCL1)/p13(MTCP1). We show that p14(TCL1)/p13(MTCP1) target PKB-PH at a site that has not yet been observed in PH-protein interactions. Located opposite the phospholipid binding pocket and distal from known protein-protein interaction sites on PH domains, the binding of dimeric TCL1 proteins to this site would allow the crosslinking of two PKB molecules at the cellular membrane in a preactivated conformation without disrupting certain PH-ligand interactions. Thus this interaction could serve to strengthen membrane association, promote trans-phosphorylation, hinder deactivation of PKB, and involve PKB in a multi-protein complex, explaining the array of known effects of TCL1. The binding sites on both proteins present attractive drug targets against leukemia caused by TCL1 proteins. | 15169787
 |
TCL1: a new drug target in lymphoid and germ-cell malignancies?
Lock, Richard B
Int. J. Biochem. Cell Biol., 35: 1614-8 (2003)
2003
Abstract anzeigen
The protein product of the T-cell leukemia/lymphoma 1 (TCL1) oncogene was recently identified as a novel Akt kinase activator. Its crystal structure predicts regions most likely involved in protein-protein interactions, and complex formation is required for TCL1 to activate Akt. TCL1 is expressed in a broad range of normal and malignant lymphoid cell types and in a high proportion of testicular seminomas of germ cell origin, indicating its potential to serve as a novel anti-cancer drug target. This review is focused on the current state of knowledge of TCL1 and the medical implications of its discovery. | 12962701
 |